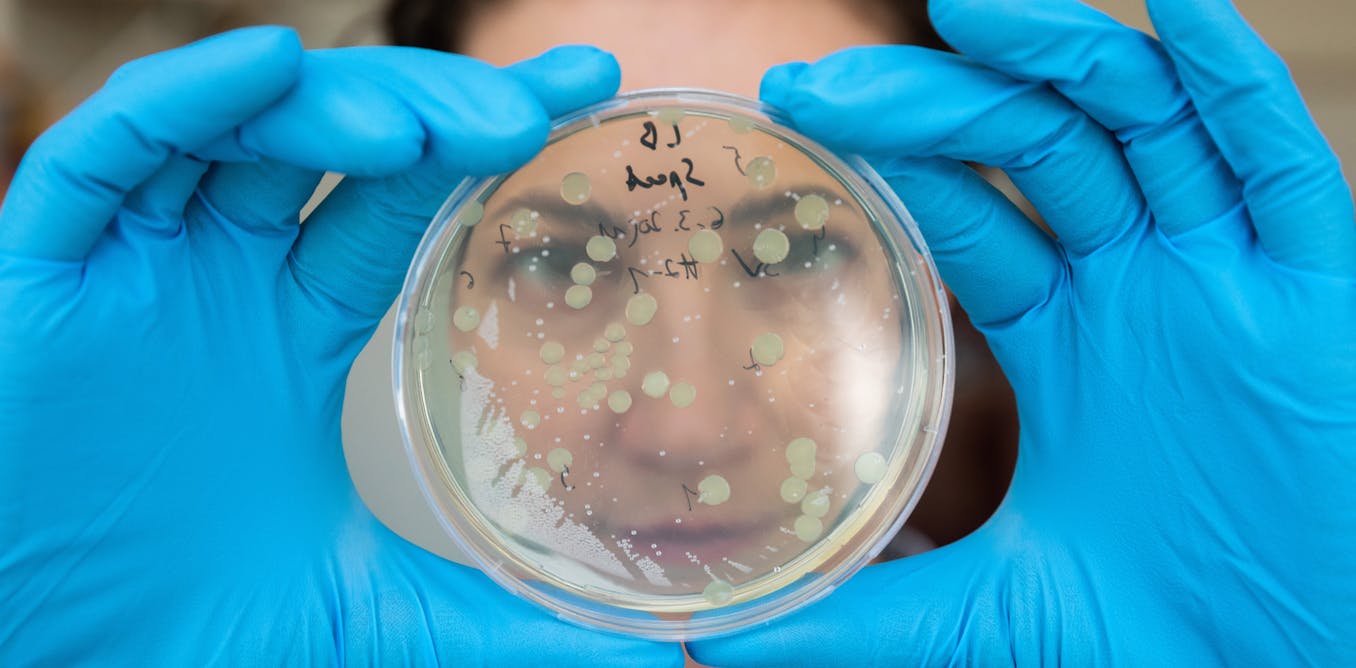

Calling the latest gene technologies 'natural' is a semantic distraction — they must still be regulated - The Conversation AU
Calling the latest gene technologies 'natural' is a semantic distraction — they must still be regulated The Conversation AU
http://dlvr.it/S8CNHn
http://dlvr.it/S8CNHn